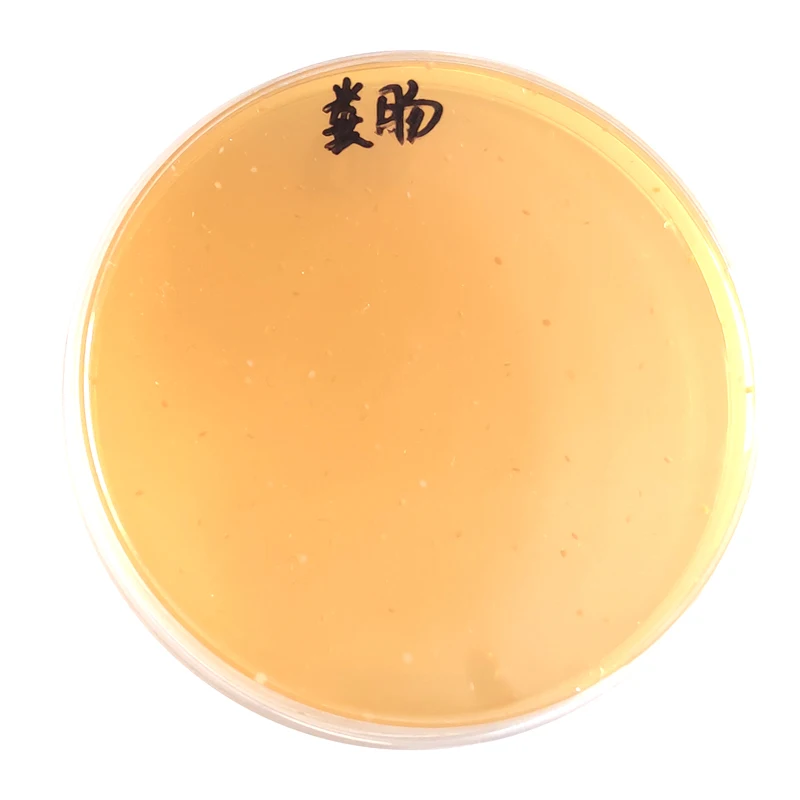

Добавка способствует росту продлевая период укладки 10 миллиардов энтерококков фекалис бустер для роста бройлеров
- Категория: >>>
- Поставщик: Shandong Yihao Biotechnology Co. Ltd.
Сохранить в закладки 1601165619958:
Описание и отзывы
Характеристики
Bacillus licheniformis for animals

[Main ingredients] Bacillus licheniformis, carrier protective agent
[Product Specifications] 200 billion CFU/g, 100 billion CFU/g, 50 billion CFU/g, 20 billion CFU/g
[Product properties] Solid powder
[ Product Features ]
This strain has the characteristics of high temperature resistance, strong stress resistance, strong enzyme production ability, and can effectively inhibit Clostridium weil. Produced by the company's unique fermentation process, the product is stable and efficient.
[ Function ]
1. It is resistant to high temperature, acid and bile salt, and is not affected by feed granulation temperature and stomach acid and bile salt of livestock and poultry. It has a high germination rate in duodenum and other small intestine, and plays a role in the form of nutrients;
2, strong enzyme production ability, can produce protease, α-amylase, cellulase, glucanase and other enzymes, while producing a variety of enzyme promoting factors, enhance the activity of animal digestive enzymes, improve feed utilization;
3, biological oxygen ability is strong, can rapidly consume free oxygen in the intestine, resulting in intestinal low oxygen, promote the rapid growth of lactic acid bacteria and other beneficial anaerobic bacteria, reduce intestinal pH, thereby inhibiting the growth of other harmful bacteria.
4, the antibacterial effect is significant, and the antibacterial liptide active substances secreted by the bacteria in the process of growth have obvious inhibitory effect on Clostridium welteri and other pathogenic bacteria.
5, improve the body's immunity, Bacillus licheniformis can stimulate the growth and development of animal immune organs, promote the phagocytosis activity of macrophages, enhance cellular and humoral immune function;
[ Scope of application ] This product is suitable for feed addition and livestock and poultry breeding.
[ Instruction ]
Feed addition: diluted step by step, directly added to animal feed, taking 100 billion CFU/g products as an example, add 30-50g per ton of full-priced compound feed (when used with Bacillus subtilis, each add 15-25g).
Drinking water: 15-25g per ton of drinking water.
| [ Note ] |
| 1. Do not use with fungicides, antibiotics, disinfectants; |
| 2. Store in a cool place away from light, avoid strong light exposure; |
| 3. The products that have not been used up after opening should be sealed in time. |
[Technical Service]
SHANDONG YIHAO BIOTECHNOLOGY CO.,LTD can help our valued customers to use this product directly!
Our mission is technology, biological and environmentally friendly!
 |  |  |
 |  |  |
OUR SERVICE


CERTIFICATION



| FAQ |
Q1:Are you manufacturer or trader ? A1:We are manufacturer. Our factory is located in Weifang city,Shandong province,China. Welcome to visit our factory at any time. |
Q2: What's the MOQ? A2: It is 1kg/bag or 25kg/bag |
Q3: How long is your delivery time? A3: Generally, it will take 7 -10 days after receiving payment receipt. |
Q4:What is the payment terms? A4:Alibaba Trade Assurance ,T/T. Western Union,MoneyGram,Alipay,PayPal etc. |
Q5:Can you accept customization? A5:Sure, we offer OEM or ODM service. The label and packaging can be made as your requirements. |
Q6: How do you control the quality? A6: First, we will test every raw materials before manufacture.And after each manufacturing step, our QC team will test again, and then all the manufacturing process finished, we will do the final test before the shipping. |
Q7: How about your service? A7: We provide 7*12 hours service and one to one business communication,convenient one-station purchasing and excellent after-sale service. |
Why choose us? |
1) Quality first with competitive price! |
2) Customer first with excellent service! |
3) Delivery in time! |
4) OEM service and make to order |
5)Online technical service for perfect application of goods! |
CONTACT US :SERVICE ONLINE |


Похожие товары
Жирные и крепкие с длинным мясом чтобы вырастить свиней из быстрых сильные жирные кормовые добавки для
Кормовые бустеры для роста крупного рогатого скота овцы увеличивают накопление жира повышают аппетит коры рыбы свиньи собаки лошади
Кормовая добавка корм для скота пищевая кукурузы клейковины 60% кормовая кукуруза а не Лучшая цена и качество
Высококачественное сено из пшеничных отрубей для оптовой продажи
Натуральный измельченный кукурузный початок порошок для выращивания грибов 60 #100 # корма крупного рогатого скота и овец
Натуральные компоненты подсолнечного шрота для формирования липидного питания жирного кислотного масла крупного рогатого скота
Высокое качество экспортный стандарт Лучшая цена очень популярный продукт удобрения для животных укрепляют здоровье DCP 18
Новые поступления
Новинки товаров от производителей по оптовым ценам